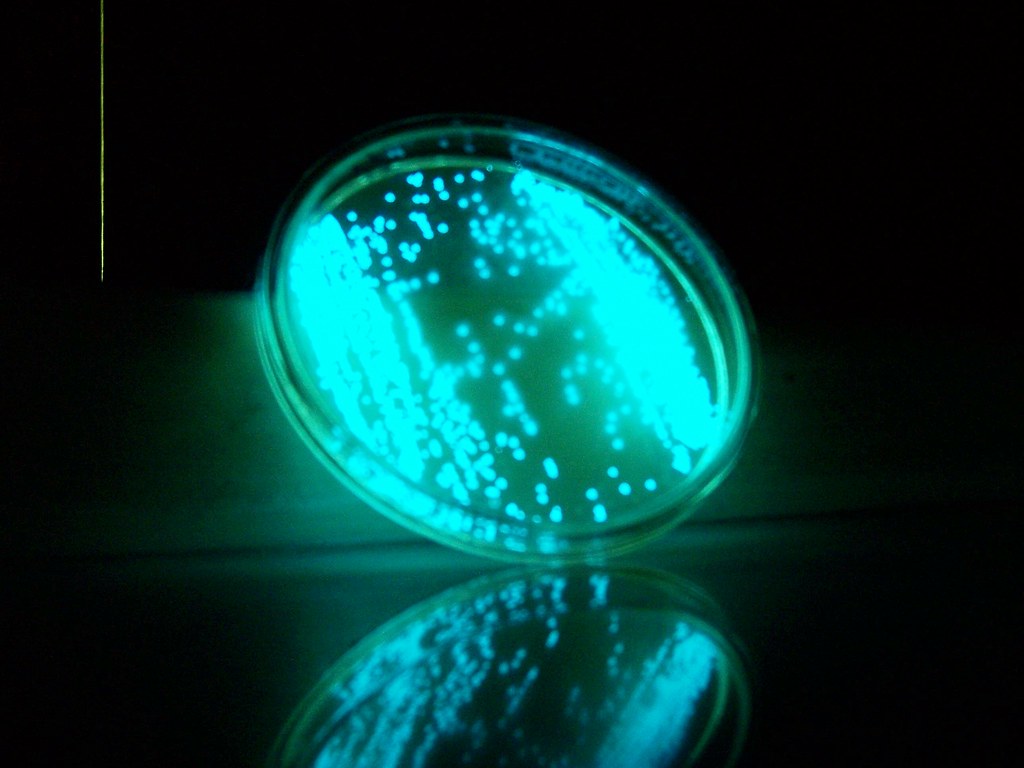

Capter la lumière physiquement

Photographie
Rainbowface and hole with others lights, 2018
50 x 110 cm
Projeter

Penser le support, les espaces




Photographies d’installation
Parallels Univers, 2016,
2 vidéo projections du film Interstellar de Christopher Nolan,
se faisant face, considération extrême du système écranique
des particules de lumière, sur les particules de lumière,
et questionne la 5e dimension (Espace-temps vibratoire)
Production CIAM La Fabrique
Living Lights
Mater / Lux / Rei
projet en cours (concours)

Pièce mêlant artificiel et vivant, je choisis de créer un espace contradictoire ou le vivant émet de la lumière, nous évoque l’état de matière primaire, la soupe cosmique originelle.
La soupe primordiale (ou primitive, ou prébiotique) est un mélange physico-chimique décrit et étudié par les scientifiques qui cherchent à comprendre, modéliser ou reproduire nos origines.
J’aime à croire que ce fut une sorte de Mater Lux Rei , une mère lumière matérielle, et que nous gardons en nous sa trace.
Pourquoi pas uniquement dans notre système mécanique de pensées :
flux lumineux qui s’active et forme, se défait, recompose, et nous laisse voir une après-midi familial au bord de la plage se matérialiser, ou amas lumineux, devenant panthère à la seule évocation du mot, signifiant et signifié formel interne.
Ici, j’ai choisi d’évoquer ce fait par un dispositif plastique qui tient son ontologie matérielle phénoménale en sa seule existence, et qui mettrait en accord Bachelard, Peschanski et Penrose : une symbiose technologique, entre biomimétique et biotechnologie. Une bioluminescence.
Mater Lux Rei est une hybridation que j’affectionne entre ancestralité et anticipation.
Une poïétique plastique à considérer.
Aller plus loin
Travail sur la lumière mnésique
Basé sur le principe d’activations d’images en neuroscience et le phénomène physique de luminosité dans le cerveau actif, ainsi que sur la composition mécaniques de souvenirs lumineux dans nos esprits, et des phénomènes scintillants lors des yeux clos, je travaille, en conscience, même de la personne performée, la lumière imaginale.
Mon essai de captage d’images avant l’endormissement
Processus :
je m’allonge dans mon lit avec un dictaphone allumé.
Je cherche à m’endormir et me laisse porter par la chimie de mon cerveau.
Ma conscience se modifie.
Je dicte les images qui passent « devant mes yeux ».
De la lumière,
Un carré blanc,
des proies en négatif,
des dictaphones,
un œil sur une brochette,
ou un crochet,
un chapeau,
le chat qui monte sur le lit,
lignes,
un point de fuite loin avec une route,
en haut en gauche,
un quart,
des lignes se tordent,
jusqu’au pointillisme,
très près,
un rien,
un carré avec une croix,
un sablier,
mon œil,
une chaînette,
une bouée,
un plateau,
des gens qui attendent,
qui marchent sur le plateau,
un chien comme un intestin,
des D majuscules,
hypnotiques,
une goutte,
un scalpel,
un cœur,
l’impression que mes oreilles se bouchent,
une fenêtre,
un enfant qui joue sur une table en bois,
une chemise à carreaux rouges,
une main avec du
vernis à ongles rouge, un doigt tendu,
un air donné,
qui y a rien aujourd’hui,
un coquillage,
un triptyque,
du mimosa,
un ange doré,
une veste,
un point,
une feuille,
larme,
un ,
un groom d’ascenseur,
un mec qui attend,
la porte s’ouvre il monte…
[…]
fin du texte dicté car l’articulation est impossible et je m’endors
Deuxième étape de travail
Stimmung 2

Premier écrit de présentation de la pièce Cosmophanie
Cosmophanie
Sculpture performance individualisée dans un espace dédié : squelettes d’animaux, plumes, bougies, pierres semies précieuses, formes en bois, bijoux, lampes, eau bénite, siège, système sonore de transmission, texte cité, participant, images intimes de ce participant, pensée matière.
600 x 350 x 200
Production La Fabrique, Le CIAM.
Une sculpture est proposée sur le mode de la parole amplifiée et transmise par le biais d’un micro et d’un casque.
Chaque personne ayant pris un rendez-vous est invitée à s’installer sur un siège et à s’isoler du monde avec le casque.
L’environnement est influencé par l’esthétique et le signifié du cabinet de psychologue/chaman.
L’offrande et le transfert sont donc supposés.
La performance est basée sur le statut mental, spirituel et/ou magique.
C’est une performance qui donne un nouveau statut aux images internes et propose une nouvelle matérialité à prendre en compte : la pensée.
Les prochains RDV sont :
Le jeudi 21 janvier 2016 de 14h à 19H
Le vendredi 22 janvier de 11H à 12H30 et de 13H30 à 19H
Le 9 février de 14H à 19H
Le mardi 12 février de 14H à 19H